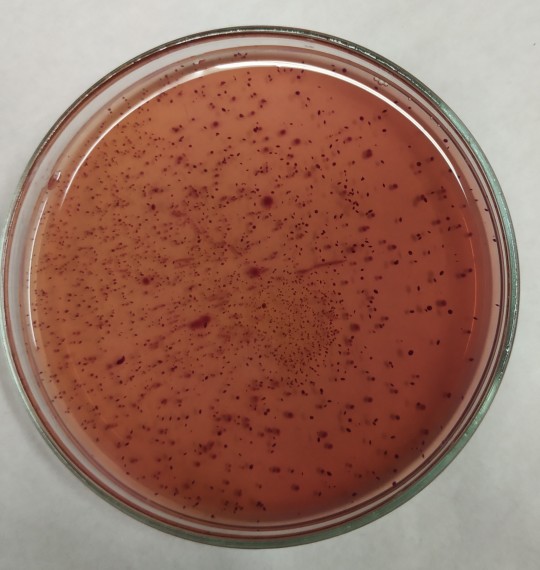
16. Enterobacteraceae na VČŽG

2.5
Mikroflóra sušeného mléka
Definice
Sušené mléko (smetana) je mléčný výrobek v prášku získaný sušením mléka plnotučného, odtučněného, částečně odtučněného, smetany nebo jejich směsi, s obsahem vody nejvýše 5 % hmotnostních.
K výrobě sušených mlék se vybírá kvalitní syrové mléko, bez inhibičních látek, bez patogenních a toxigenních mikroorganizmů.
Mléko se suší v rozprašovacích sušárnách v proudu sušícího vzduchu. Teplota sušícího vzduchu je 150 – 200 °C. Sušením se odebírá z výrobku voda, aktivita vody výrobku klesá až na aw = 0,3 – 0,2. Trvanlivost sušených mléčných výrobků je zaručena procesem sušení a správným skladováním.
Velmi přísně se vybírá surovina pro výrobu dětské a kojenecké výživy. Jsou zvýšené nároky na hygienicko-sanitační režim, zvýšené nároky na jakost finálního výrobku, mikrobiologické hodnocení výrobku probíhá ihned po výrobě a následně se mléko asepticky balí.
Mikroorganizmy v sušeném mléce přežívající výrobní proces: sporotvorné bakterie (Bacillus cereus), nesporotvorné termorezistentní mikroorganizmy – Streptococcus faecium, Enterococcus faecalis a Streptococcus thermophilus, Micrococcus, Sarcina.
Do mléka se mohou dostat mikroorganizmy po sušení nebo v jeho průběhu – např. Staphylococcus aureus, salmonely, Enterobacteriaceae, koliformní b., E. coli, Cronobacter sakazakii, kvasinky, plísně (Aspergillus, Penicillium, Rhizopus, Cladosporidium, atd.)
K rozvoji mikroflóry dochází při zvýšení aw prášku nad 0,7 při skladování.
Při výrobě může docházet ke kontaminaci mléka ze špatně sanitovaného zařízení, ze vzduchu při instantizaci nebo dopravě prášku, nebo při balení. Ke zvlhnutí prášku může dojít také u spotřebitele po otevření balení a jeho nevhodném skladování – ! rozvoj toxinogenních plísní Cladosporium a Rhizopus.
Po obnovení mléka dochází k prudkému rozvoji mikroorganizmů a mohou tak způsobovat vážné problémy zejména u kojenců. Proto je nutné mléko po obnovení ihned spotřebovat a zbylý prášek skladovat přesně podle pokynů výrobce.
+
Obr. 16. Enterobacteraceae na VČŽG